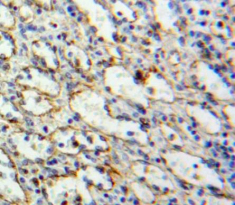

Polyclonal Antibody to Surfactant Protein C (SP-C)


Product No.: PAB623Hu01
Organism species: Homo sapiens (Human)

Monoclonal Antibody to Surfactant Protein C (SP-C)


Product No.: MAB623Hu22
Organism species: Homo sapiens (Human)

Polyclonal Antibody to Myeloid Differentiation Factor 88 (MyD88)


Product No.: PAB707Hu01
Organism species: Homo sapiens (Human)
Monoclonal Antibody to Myeloid Differentiation Factor 88 (MyD88)


Product No.: MAB707Hu22
Organism species: Homo sapiens (Human)

Polyclonal Antibody to Toll Like Receptor 7 (TLR7)


Product No.: PAB950Hu01
Organism species: Homo sapiens (Human)
Monoclonal Antibody to Toll Like Receptor 7 (TLR7)


Product No.: MAB950Hu22
Organism species: Homo sapiens (Human)

Polyclonal Antibody to Toll Like Receptor 1 (TLR1)


Product No.: PAB988Hu01
Organism species: Homo sapiens (Human)
Monoclonal Antibody to Toll Like Receptor 1 (TLR1)


Product No.: MAB988Hu22
Organism species: Homo sapiens (Human)

Polyclonal Antibody to Toll Like Receptor 3 (TLR3)


Product No.: PAB989Hu01
Organism species: Homo sapiens (Human)
Monoclonal Antibody to Toll Like Receptor 3 (TLR3)


Product No.: MAB989Hu22
Organism species: Homo sapiens (Human)

Polyclonal Antibody to Toll Like Receptor 5 (TLR5)


Product No.: PAB990Hu01
Organism species: Homo sapiens (Human)

Polyclonal Antibody to Toll Like Receptor 8 (TLR8)


Product No.: PAB991Hu01
Organism species: Homo sapiens (Human)
Monoclonal Antibody to Toll Like Receptor 8 (TLR8)


Product No.: MAB991Hu22
Organism species: Homo sapiens (Human)
Polyclonal Antibody to Toll Like Receptor 10 (TLR10)


Product No.: PAB992Hu01
Organism species: Homo sapiens (Human)
Monoclonal Antibody to Toll Like Receptor 10 (TLR10)

